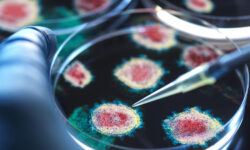
Владимир Болибок и Александр Лукашев об успехах России в изучении COVID-19 с ВОЗ vladimir bolibok i aleksandr lukashev ob uspehah rossii v izuchenii 19 s voz-ul-rks-ru-174230914000-0

Показатели летальности от последнего штамма коронавируса NB.1.8.1 продолжают оставаться значительными — общий уровень достигает 0,5%. Об этом сообщил врач аллерголог-иммунолог Владимир Болибок.
— У пациентов, требующих госпитализации, риск летального исхода составляет 5%, — подчеркнул специалист. — В группе особого внимания — люди старше 65 лет и страдающие хроническими заболеваниями. В таких случаях показатель увеличивается до 8%.
Профилактика и прогнозы эксперта
Болибок обратил внимание на необходимость готовности к активной циркуляции вируса. Он рекомендовал носить маски в местах скопления людей: это снизит дозу патогена при возможном заражении, уменьшив вероятность тяжелого течения болезни.
Также иммунолог отметил, что 15% переболевших новым геновариантом сталкиваются с постковидным синдромом, но своевременные меры защиты помогут избежать осложнений.
Рекомендации для сохранения здоровья
Соблюдение простых правил профилактики, по словам эксперта, остаётся ключом к контролю над ситуацией. Специалист призвал сосредоточиться на укреплении иммунитета и не пренебрегать средствами индивидуальной защиты.
Источник: vm.ru